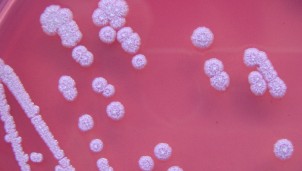
Vi khuẩn chết người Whitmore lần đầu tiên được tìm thấy ở Hoa Kỳ

TikTok triển khai hệ thống cảnh báo lừa đảo trực tiếp trong ứng dụng
Nền tảng TikTok hôm nay (18-11) công bố bước chuyển mới trong chiến dịch chống lừa đảo trực tuyến bằng việc gửi cảnh báo trực tiếp tới người dùng ngay trong ứng dụng. Đây là lần đầu tiên TikTok triển khai đồng bộ việc gửi cảnh báo về lừa đảo trực tuyến đến với người dùng toàn quốc ngay trên nền tảng.
Tin đọc nhiều
Đóng điện dự án Trạm biến áp 220kV Chư Sê và đấu nối: Tăng cường giải tỏa nguồn năng lượng tái tạo trong khu vực

Vào lúc 9h50 phút, ngày 1/8, tại Gia Lai, Ban QLDA các công trình điện miền Trung (CPMB) phối hợp với các đơn vị liên quan tổ chức nghiệm thu, đóng điện dự án Trạm biến áp 220kV Chư Sê và đấu nối.
Bộ Tài chính bổ sung quy định về thủ tục nhập khẩu, tạm nhập khẩu xe ô tô, xe gắn máy

Bộ Tài chính đã giao cho Tổng cục Hải quan thực hiện kiểm soát, quản lý các thông tin liên quan đối với việc nhập khẩu, tạm nhập khẩu xe ô tô, xe gắn máy của các đối tượng được phép nhập khẩu, tạm nhập khẩu không nhằm mục đích thương mại.
Đóng điện thông tuyến đường dây 500kV mạch 3

Vào lúc 20h ngày 31/7, Tổng công ty Truyền tải điện Quốc gia (EVNNPT)/Ban Quản lý dự án các công trình điện miền Trung (CPMB) phối hợp với các đơn vị liên quan đóng điện kỹ thuật Đường dây 500kV Vũng Áng – Quảng Trạch. Sau khi đóng điện, toàn bộ dự án Đường dây 500kV mạch 3 Vũng Áng - Quảng Trạch - Dốc Sỏi – Pleiku 2 được thông tuyến.
Vi khuẩn chết người Whitmore lần đầu tiên được tìm thấy ở Hoa Kỳ
Trung tâm Kiểm soát và Phòng ngừa Dịch bệnh Mỹ (CDC) công bố lần đầu tiên tìm thấy vi khuẩn gây ra căn bệnh có khả năng gây tử vong melioidosis (hay bệnh Whitmore) được tìm thấy trên đất Mỹ. Phát hiện này diễn ra trong thời gian New York đang phải ban bố tình trạng khẩn cấp y tế vì bệnh đậu mùa khỉ.
Đại sứ Hoa hậu áo dài Việt Nam 2022 Phạm Thu Thủy: Hành trình nào đối với các thí sinh cũng là đáng nhớ

Tiếp nối truyền thống quý báu và sứ mệnh quảng bá tà áo dài trên mọi miền Tổ quốc, đồng thời đưa hình ảnh những chiếc áo dài Việt Nam vươn ra khắp 5, cuộc thi Hoa hậu áo dài Việt Nam 2022 đã diễn ra với nhiều điểm nhấn quan trọng.
Điện tâm đồ - theo dõi trái tim của bạn

Các bệnh về tim (CVD) là nguyên nhân gây tử vong nhiều nhất năm 2008, chiếm tới 30% các ca tử vong trên khắp thế giới vào năm đó. Để chăm sóc và phát hiện sớm các bất thường của tim, các nhà khoa học đã phát triển nhiều công cụ theo dõi nhịp tim, và phương pháp được biết đến rộng rãi nhất là điện tâm đồ.
Máy khử rung tim: Bảo vệ trái tim người bệnh

Máy khử rung tim (Defibrillator) là một trong số những thiết bị y tế quan trọng nhất trong lịch sử con người. Lần đầu được thử nghiệm vào năm 1899 bởi Jean-Louis Prévost và Frédéric Batelli, hai nhà sinh lý học từ Đại học Geneva, Thụy Sĩ. Chiếc máy đã giúp cải thiện cuộc sống của nhiều bệnh nhận bị bệnh tim.
Chụp cộng hưởng từ là gì và phân loại các máy chụp cắt lớp tốt nhất

Chụp cộng hưởng từ (hay MRI - Magnetic Resonance Imaging) là một phương pháp thu hình ảnh của các cơ quan trong cơ thể sống và quan sát lượng nước bên trong các cấu trúc của các cơ quan. Từ hình ảnh thu được, bác sĩ có thể chuẩn đoán được tình trạng sức khỏe của bệnh nhân, có thể phát hiện sớm nhiều căn bệnh nguy hiểm cũng như theo dõi quá trình điều trị.


















